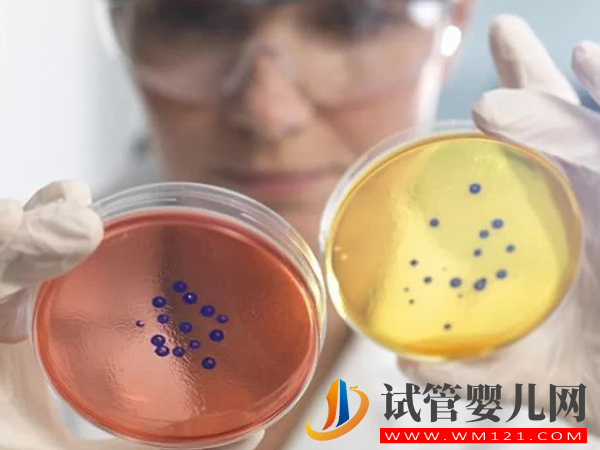
還不了解第四代試管嬰兒,兩個技術提高大齡女性成功率(圖1) 還不了解第四代試管嬰兒,兩個技術提高大齡女性成功率(圖1)

還不了解第四代試管嬰兒,兩個技術提高大齡女性成功率
試管嬰兒技術一直在穩(wěn)步發(fā)展中,經(jīng)歷了第一代、第二代、第三代,現(xiàn)在已經(jīng)發(fā)展到第四代技術了,雖然還不是很成熟,但也讓想要生育的高齡女性看到了希望,但大家都還不是很了解第四代試管嬰兒技術,所以什么是第四代試管成為了大家最想知道的問題。
什么是第四代試管嬰兒技術
現(xiàn)在四代試管技術臨床上應用的還不多,大部分了解到的都是來源于基礎理論上,而且目前關于第四代技術也是爭議不斷,根據(jù)數(shù)據(jù)顯示,這項試管嬰兒技術將極大的改善卵子質量問題,有望提升高齡女性30%左右的試管嬰兒成功率。
2016年4月,世界上“一父二母”的試管嬰兒的誕生,標志著第四代試管嬰兒胚漿置換技術(GVT)成功運用,但因為受限于醫(yī)學、倫理、安全等方面的爭議,目前僅處于研究階段并沒有在臨床上廣泛應用。

從搜集的資料中能了解到,針對“第四代試管嬰兒技術”共有卵漿質置換技術(GVT)和卵子干細胞技術(EggPCSM)兩種說法:
- 1. 卵漿質置換技術(GVT)又稱三人試管嬰兒技術,意思是通過老化卵子和年輕卵子之間做卵核置換,利用老化卵子的基因加上年輕卵子的細胞質來合成新的卵子,從而更好地應對老化卵子的問題,提高大齡女性的妊娠可能性;
- 2. 卵子干細胞技術(EggPCSM)主要根據(jù)是獲取女性自身的卵巢干細胞,提取出其中的線粒體,并將這些線粒體注射到她自身的卵細胞,以提高卵細胞的質量,但目前都沒有進行過正式的臨床試驗,更談不上進入臨床應用了。





